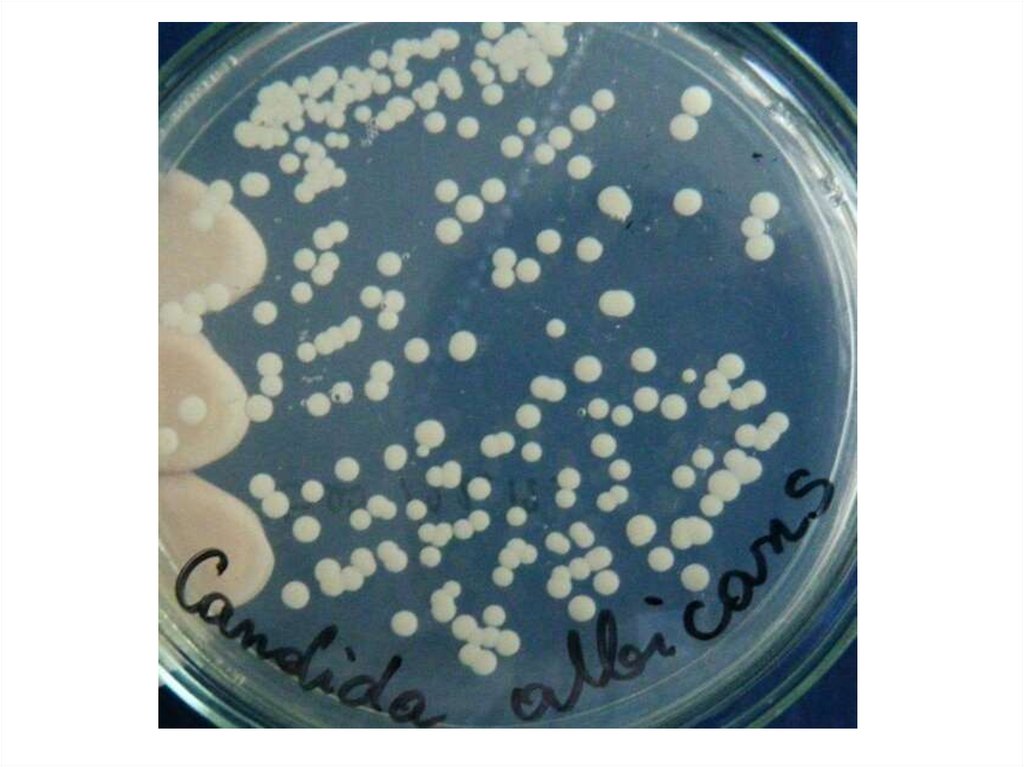
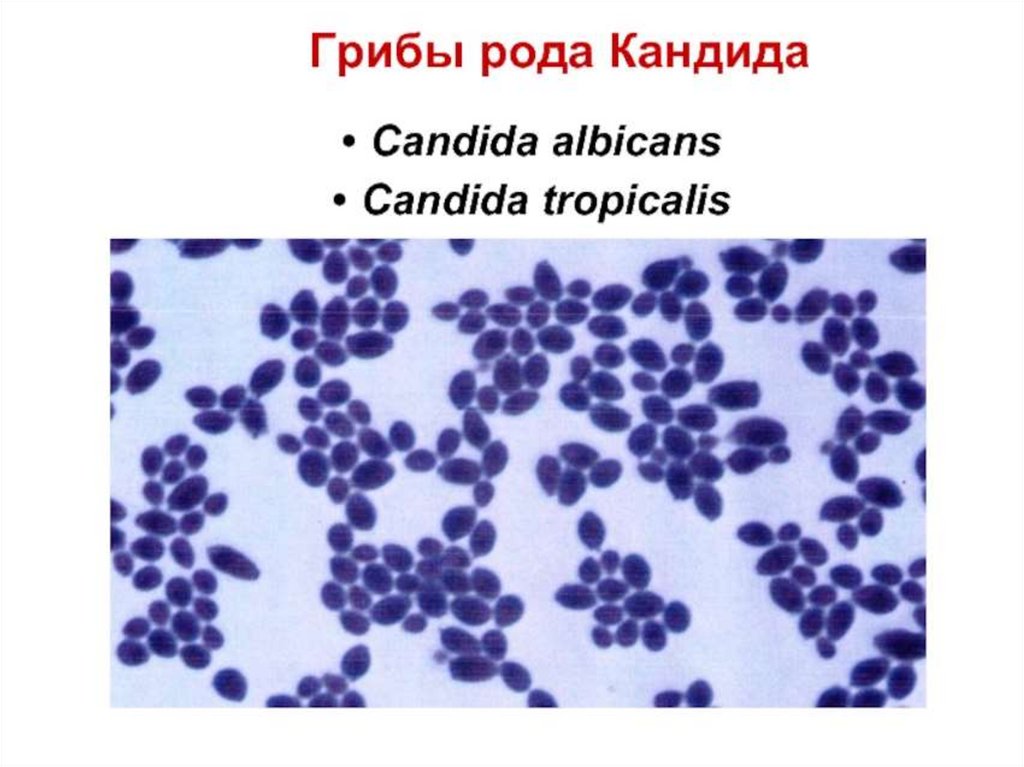

Similar presentations:
Царство Грибы (Mycota)
1.
Царство Грибы (Mycota)Гифы – тонкие ветвящиеся нити, мицелий, грибница.
Низшие грибы – фикомицеты (нет перегородок в нитях, 1
гигантская клетка с большим числом ядер)
Высшие грибы – эумицеты (гифы разделены септами –
перегородками 1-2 ядра содержат.
Оболочка (хитин), ядро, ядерная мембрана, МХ, ЛЗ, ЭПС,
аппарат Гольджи, вакуоли с гликогеном.
Размножение – вегетативное, бесполое, половое (споры)
• род Mucor
• род Aspergillus
• род Penicillium
• Дрожжи
• Claviceps purpura
• Род Candida

biology
biology








